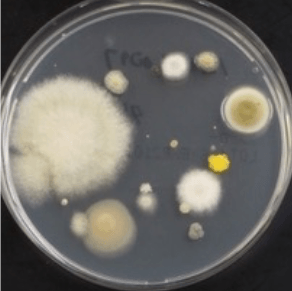
1日使用したマスクの外側を用いて真菌を培養したプレート

世界初!マスクの使用実態と付着する細菌・真菌について検証 コロナ禍で習慣となったマスク着用の衛生的な方法の啓発に活用

近畿大学医学部(大阪府大阪狭山市)微生物学教室講師 朴 雅美を中心とする研究グループは、アンケートによってマスク使用の実態調査を実施するとともに、使用済みマスクに付着する細菌・真菌※1 を培養し、数と種類を同定しました。マスクに付着した細菌と真菌は、多くが無害な菌でしたが、一部有害な菌も検出されました。本研究は、マスクの使用状況や生活習慣と、マスクに付着する細菌・真菌との関連性を解析した世界で初めての研究であり、その成果はコロナ禍で習慣となったマスク着用について、衛生的で正しい方法の啓発に活用できます。
なお、本研究は"オール近大"新型コロナウイルス感染症対策支援プロジェクトの一環として実施されました。
本件に関する論文が、令和4年(2022年)7月18日(月)18:00(日本時間)に、自然科学分野を対象とした科学雑誌"Scientific Reports"にオンライン掲載されました。
【本件のポイント】
●マスクの使用実態と、内側・外側に付着する細菌・真菌に着目した世界初の研究
●有害な菌も検出されたことから、マスクは1日程度で交換することを推奨
●本研究成果を生かし、コロナ禍で習慣となったマスク着用において、衛生的で正しい方法を啓発
【本件の背景】
コロナ禍において、常時マスクを着用する新しい生活スタイルが定着しました。不織布マスクのウイルス感染に対する有効性は広く研究されており、屋内や会食をする場面では着用が推奨されています。一方で、使用済みマスクの衛生面、特に付着した細菌や真菌の実態に着目した研究はありませんでした。細菌や真菌は日用品などから高頻度に検出されますが、なかには身体に害をもたらし、病気を引き起こす原因となる微生物も存在しています。
【本件の内容】
本研究では、109人のボランティアにマスク使用に関するアンケート(素材、使用日数など)を実施して使用実態を調査するとともに、マスクの内側・外側それぞれに付着した細菌と真菌を培養し、菌の数および種類を調べました。
その結果、細菌の数はマスクの内側で多い一方、真菌の数はマスクの外側で多いことが明らかになりました。また、マスクの使用日数が長いほど、真菌の数は有意に増加しましたが、細菌の数は増加しませんでした。さらに、性別や日々の習慣と菌数・菌種の関係を調べた結果、公共交通機関の利用有無や、うがいの習慣などの条件が菌の増減に影響することはありませんでした。
今回の研究で検出された細菌・真菌の大部分は通常病気を起こさない菌でしたが、黄色ブドウ球菌、腐性ブドウ球菌、シュードモナス・ルテオラ菌、ケカビ、アスペルギルス、フォンセカエなどの、病気の原因となる菌も検出されたことから、マスクの継続使用には注意が必要であり、1日程度で交換することが推奨されます。また、有害な菌はマスクの外側で検出される頻度が高いことから、使用しているマスクの外側と内側を間違って装着することがないように気をつける必要があります。
このように、本研究成果は、コロナ禍で新たな習慣となったマスク着用について、衛生的で正しい方法の啓発に活用できます。
【論文掲載】
掲載誌:Scientific Reports(インパクトファクター:4.996@2022)
論文名:
Bacterial and fungal isolation from face masks under COVID-19 pandemic
(新型コロナウイルス感染症パンデミックにおける使用マスクからの細菌と真菌の単離)
著 者:
朴 雅美※、スンダル・カドカ、佐藤 文孝、尾村 誠一、藤田 貢、橋脇 和樹、角田 郁生
※ 責任著者
所 属:近畿大学医学部微生物学教室(著者、共著者の所属は執筆当時)
【研究詳細】
本研究では、令和2年(2020年)9~10月の2カ月間に、ボランティアの被験者109人に対してWEBアンケート調査を実施しました。その結果、使用するマスクの種類は、不織布マスクが78%を占め、それ以外の大部分はウレタンマスクであり、ガーゼマスクや布製マスクの使用も少数あることが分かりました。また、不織布マスク使用者の75%は1日で使い捨てていましたが、3日以上使用している人が14%いることも明らかになりました。
さらに、アンケート回答者全員の使用済みマスク約200枚を用いて、内側・外側それぞれを細菌もしくは真菌培養用の一般的なプレートに押し当て、細菌用は37℃で一晩、真菌用は25℃で5日間培養しました。その結果、細菌・真菌ともに、全てのマスクから検出されましたが、細菌の方がより数が多いことが分かりました。細菌数はマスクの外側と比べて内側に多く、ほとんどが皮膚常在菌でしたが、マスクの外側からは糞便に由来し食中毒を起こすセレウス菌なども検出されました。また、納豆を食べる習慣がある人のマスクからは、本検査期間中に納豆を食べていなくても高頻度に納豆菌(枯草菌)が検出されました。これはマスクの内側、外側両方から検出されましたが、身体に影響を与えるものではありません。納豆菌は芽胞※2 という種のようなものを作るため、熱や乾燥に強く、死滅しにくいことがわかっており、そのため納豆を食べる習慣がある人の身の回りには納豆菌が常に存在していると考えられます。
一方、真菌はマスクの外側に多く付着しており、一般的な黒カビや水虫の原因となる白癬菌などが検出されました。数日間使用を続けたマスクでは、細菌数は増加が見られなかったのに対し、真菌数は増加していました。これは、多くの細菌が乾燥に弱く、マスクを着用していない夜間などに乾燥して死滅するのに対し、真菌は比較的乾燥に強く、胞子などを作るものが多いため、死滅することなく付着し続け、数日間の間に蓄積されたのではないかと推測されます。
さらに、性別や日々の習慣と菌数・菌種の関係を調べた結果、男性で細菌がやや多く検出された以外は、公共交通機関の利用有無やうがいの習慣などの条件が菌の増減に影響することはありませんでした。一方、洗顔や化粧水の使用などスキンケアを多く行なっている人ほど検出される細菌数が少ないことが判明し、洗顔をしない場合は増加していました。また、糞便に由来する菌は病原性を持つものが多いため、正しく洗浄できていない手でマスクを触ると有害な菌が付着する可能性が上がると考えられます。
本研究で検出された細菌・真菌のほとんどは通常は病気を起こさない菌でしたが、なかには免疫機能が低下している人に対して病気を引き起こす可能性がある、黄色ブドウ球菌、腐性ブドウ球菌、シュードモナス・ルテオラ菌、ケカビ、アスペルギルス、フォンセカエなども検出されました。そのため、マスクの継続使用には注意が必要であり、1日程度で交換することが推奨されます。また、マスクの外側は病気の原因となる菌が検出される頻度が高いことから、使用しているマスクの外側と内側を間違って装着することがないように気をつける必要があります。
なお、本研究は9~10月に実施しましたが、真菌の種類は季節で変化することから、同様の研究を異なる季節に実施することで、新たな知見が得られるのではないかと考えられます。
日本では、コロナ禍以前より、花粉症対策などでマスク使用が他国より日常生活に浸透していることが知られていました。本研究成果は、コロナ禍だけでなく、今後の衛生的なマスク着用の方法を考えるうえで、有効活用されることが期待されます。
【"オール近大"新型コロナウイルス感染症対策支援プロジェクト】
「"オール近大"新型コロナウイルス感染症対策支援プロジェクト」とは、近畿大学が令和2年(2020年)5月から実施しているもので、世界で猛威をふるう新型コロナウイルス感染症について、医学から芸術までの研究分野を網羅する総合大学と附属学校等の力を結集し、全教職員から関連研究や支援活動の企画提案を募って行っている全学横断プロジェクトです。これまでに126件の企画提案が採択され、約2億2千万円の研究費をかけて実施しています。
【用語解説】
※1 細菌・真菌:ともにウイルスの数十倍の大きさがあるが、肉眼では見ることができない小さい生物。細菌には、肺炎や食中毒などの病気を起こすものや、納豆菌・乳酸菌など食品に用いられるもの、健康に多くの影響を与える腸内フローラなど、様々なものがある。真菌には、肺炎や皮膚炎などの病気を起こすものや、食品に利用されるものなど様々な種類があり、カビ、酵母、キノコなども含まれる。
※2 芽胞:一部の細菌が、生存に不適な環境で形成する、耐久性の高い細胞構造。熱・薬剤・乾燥などに強い抵抗力を示し、長期間休眠状態を維持できる。生存に適した環境になると発芽して菌体に戻る。
【関連リンク】
医学部 医学科 講師 朴 雅美(パク アミ)
https://www.kindai.ac.jp/meikan/1601-ah-mee-park.html
医学部 医学科 講師 佐藤 文孝(サトウ フミタカ)
https://www.kindai.ac.jp/meikan/2240-sato-fumitaka.html
医学部 医学科 講師 尾村 誠一(オムラ セイイチ)
https://www.kindai.ac.jp/meikan/2226-omura-seiichi.html
医学部 医学科 准教授 藤田 貢(フジタ ミツグ)
https://www.kindai.ac.jp/meikan/658-fujita-mitsugu.html
医学部 医学科 教授 角田 郁生(ツノダ イクオ)
https://www.kindai.ac.jp/meikan/1503-tsunoda-ikuo.html

















